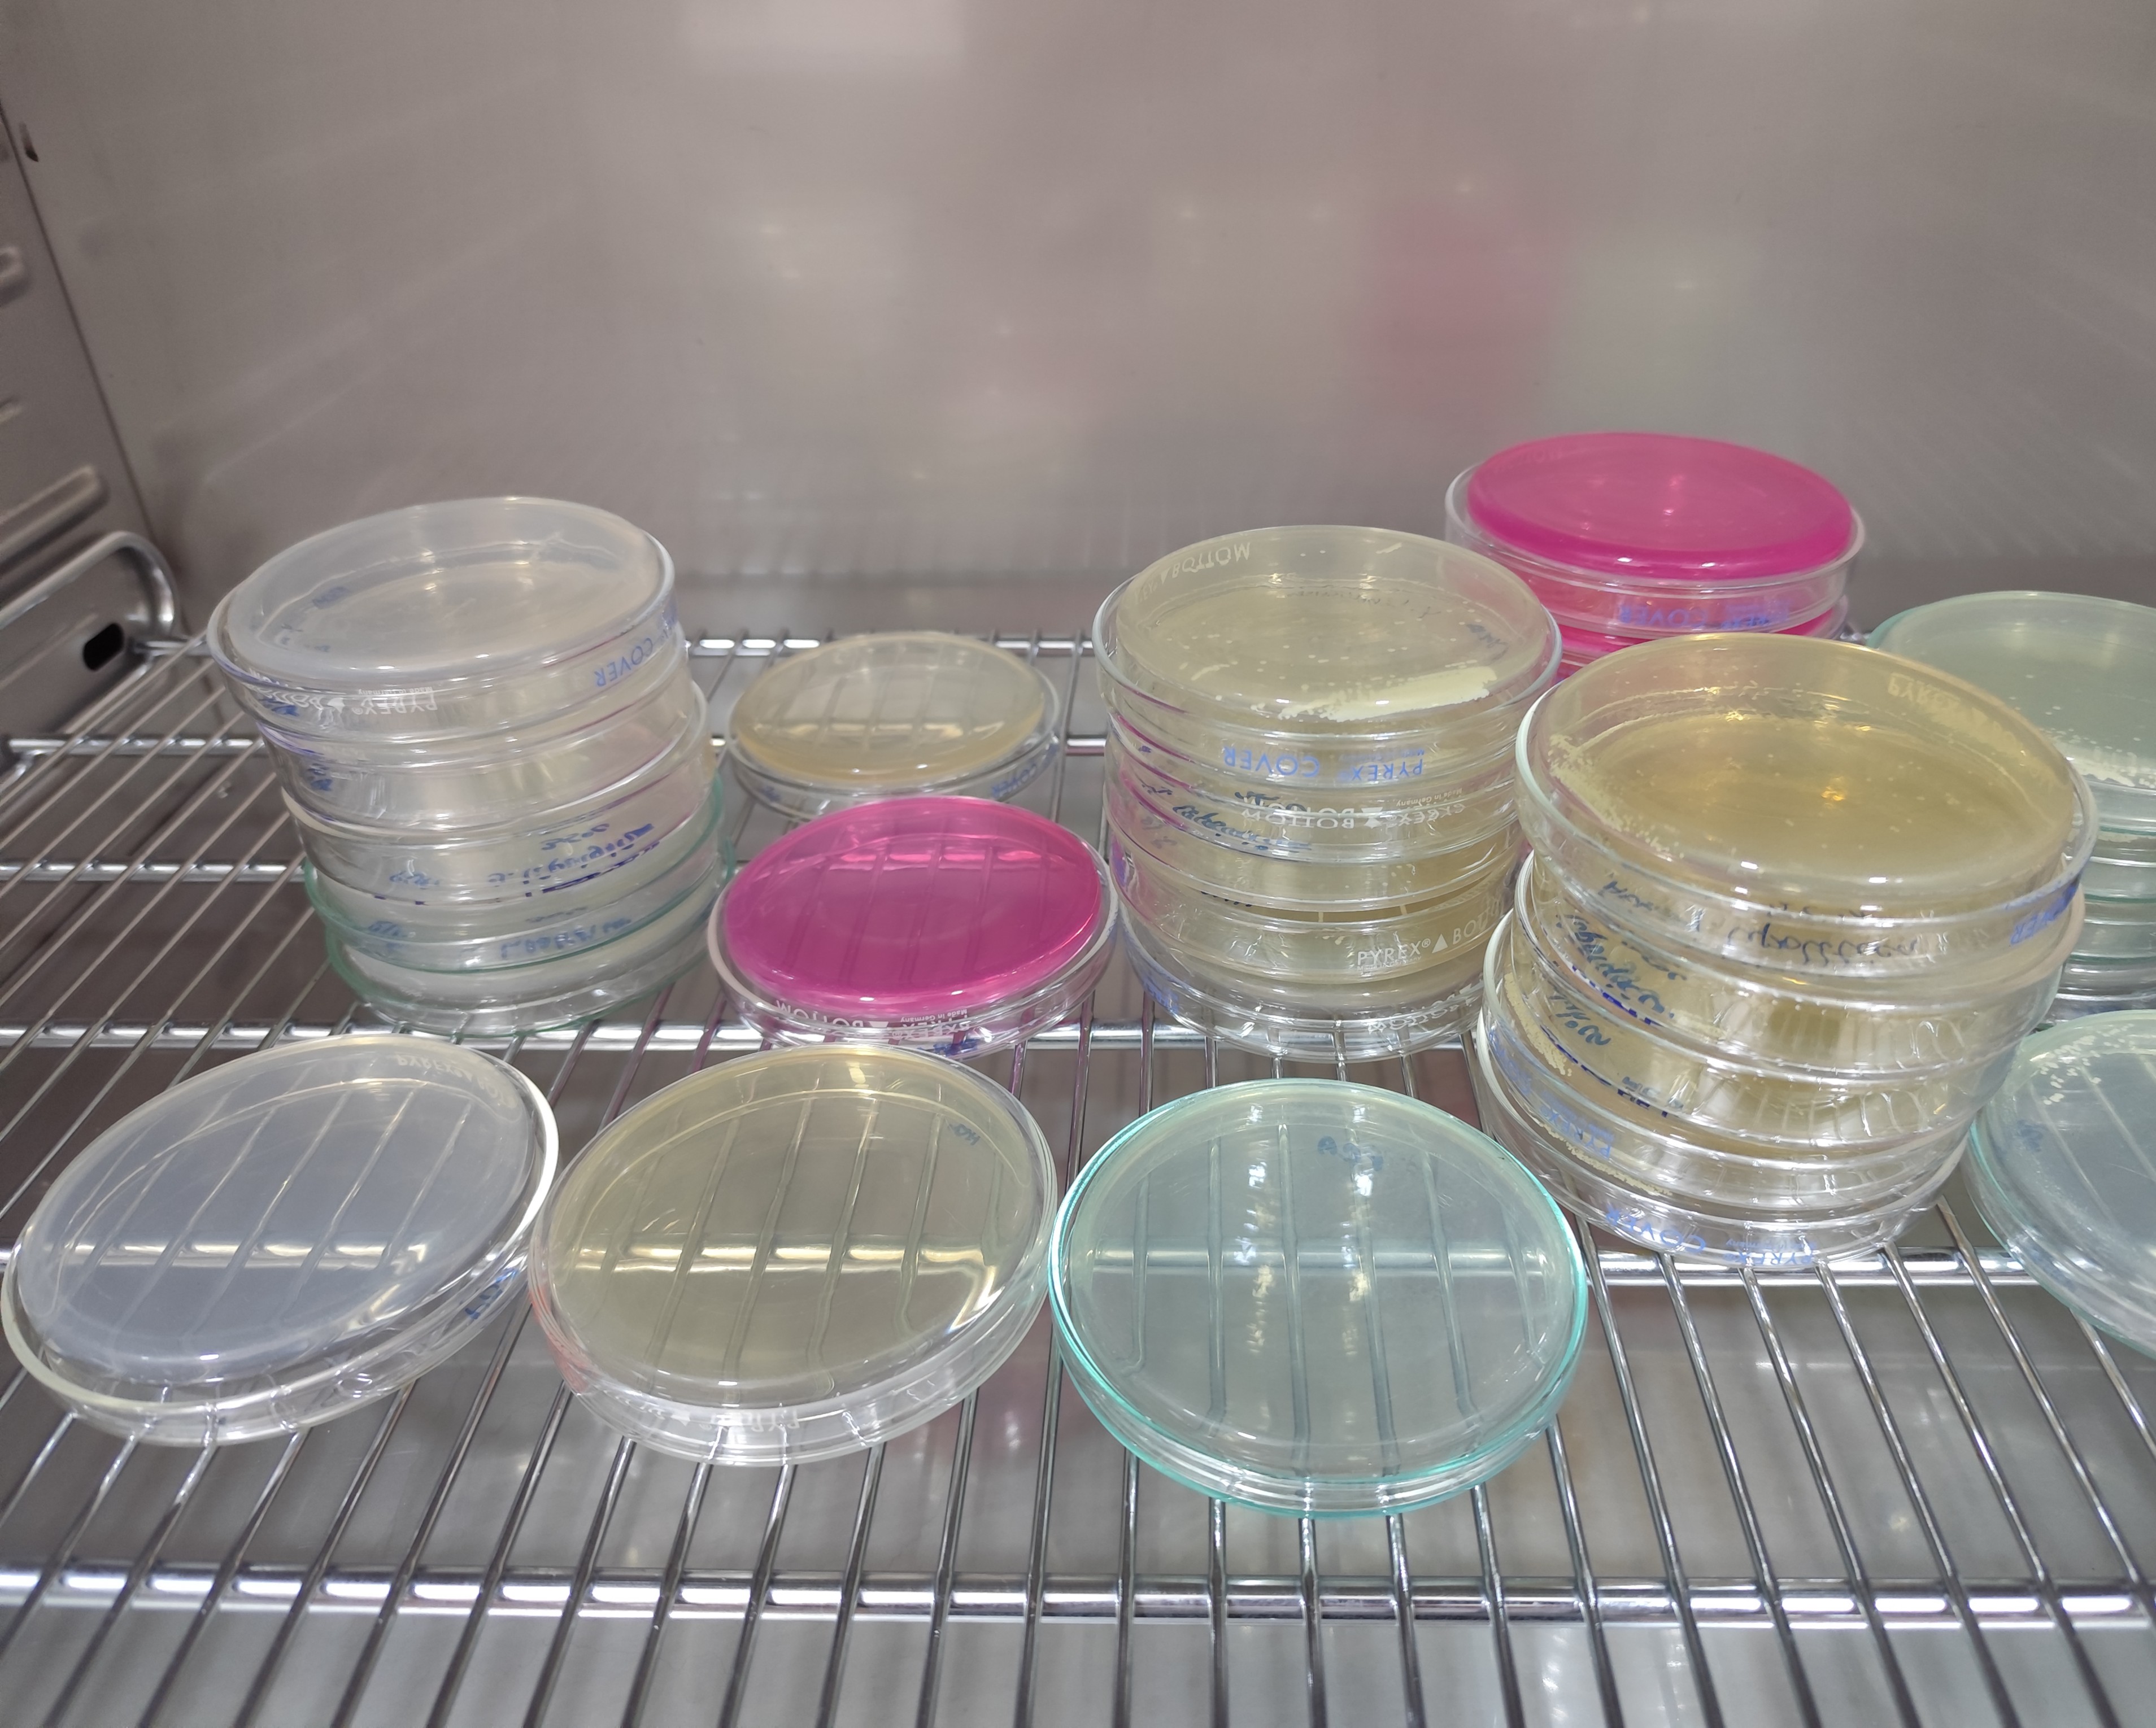
Ciepe-Nota-Tecnica

La Fundación CIEPE realizó Evaluación del crecimiento de la levadura Yarrowia lipolytica aislada de un queso madurado.
La Yarrowia, es una levadura no patógena que recibe la denominación de "Lipolytica" por la capacidad que tiene de hidrolizar grasas, a esto se debe su presencia en productos lácteos, causando efectos beneficiosos como el proceso de maduración. Esta levadura particular, tiene elevada capacidad de excretar diversas proteínas como lipasa, proteasa y RNAsas, y puede desarrollar características de diformismo según las condiciones de cultivo, ya que puede crecer en forma levaduriforme o formar pseudo-hifas. Adicionalmente tiene la capacidad de adaptarse a condiciones adversas de crecimiento en cuanto a concentraciones de sal, pH y temperatura.
La industria alimenticia y farmacéutica, han mostrado gran interés en el estudio de las levaduras, como alternativa viable para la generación de bioinsumos de alto impacto a bajo costo, para mejorar los procesos de producción y desarrollo de productos.
La División de Microbiología, evaluó el crecimiento de la levadura, Yarrowia lipolytica, aislada en un alimento, específicamente, en el queso madurado, la finalidad del estudio fue realizar una caracterización base, que conduzca a otras investigaciones, así mismo, determinar su crecimiento óptimo y establecer su potencial como bioinsumo en la industria de los alimentos, incluyendo las formulaciones de alimentos balanceados para peces, por su alto valor proteico.